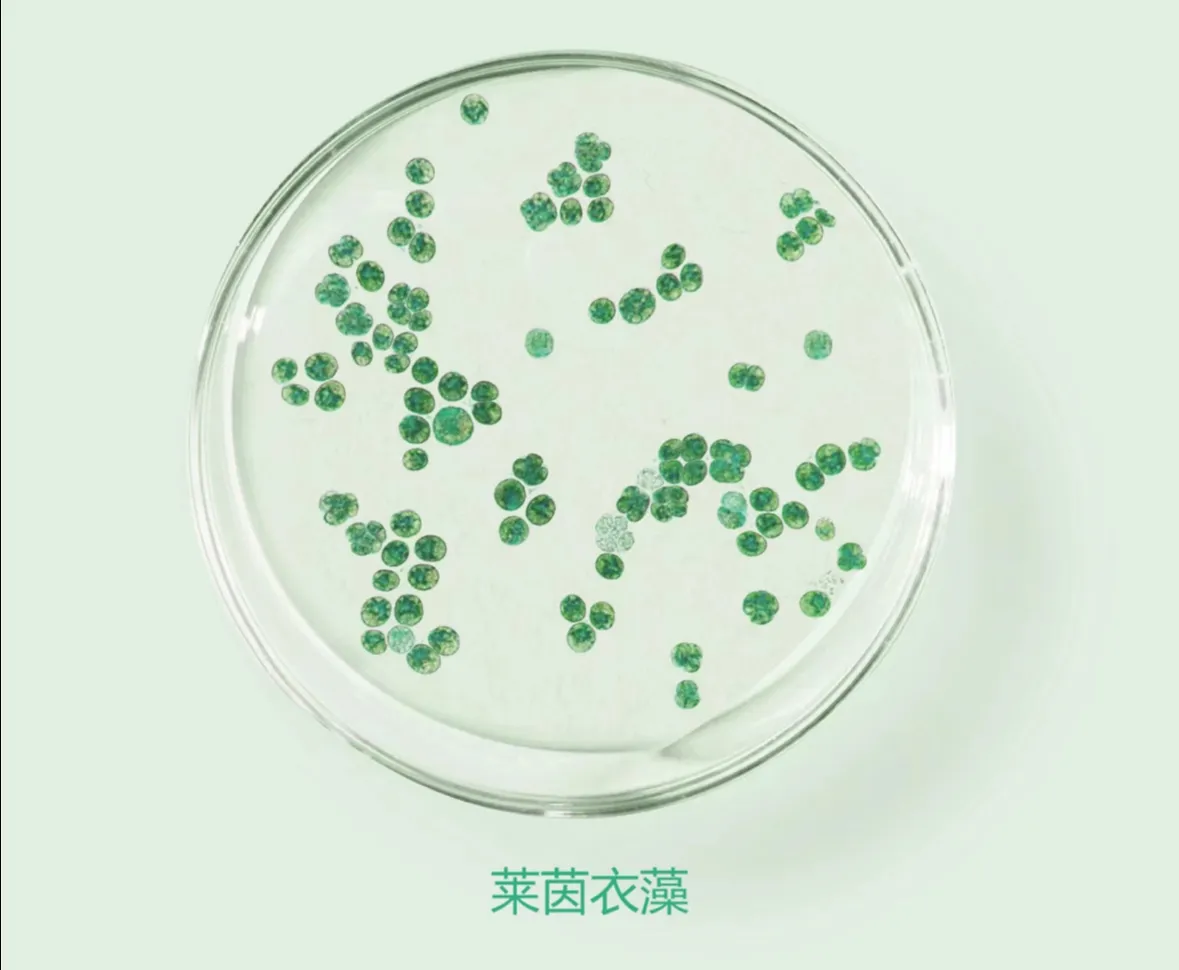

造纸行业产生大量废水,未经有效处理排放会严重污染环境,高效环保的尾水处理技术成为重要课题。菌藻共生系统作为新兴生物技术在其中展现巨大潜力。 该系统由相互依存、作用的细菌和藻类构成,形成复杂稳定的生态平衡,具有高效、节能、低耗优点。在造纸尾水处理中,通过细菌分泌酶分解大分子有机物,藻类吸收小分子有机物,去除有机物;细菌硝化和反硝化去除氮,藻类吸收磷,去除氮磷营养物质;藻类和细菌吸附、络合吸收重金属有害物质。 实现其有效应用要注意:根据废水特点选择和培养合适菌藻种类;精确控制温度、光照、pH 值、溶解氧等反应条件;定期监测水质指标,调整参数,维护系统运行。菌藻共生系统优势显著,能达标处理废水,成本低、能耗少、环保,未来有望在造纸尾水处理中发挥更重要作用,推动行业可持续发展与环保。…
尾水处理(一):菌藻共生系统在造纸行业尾水中的应用